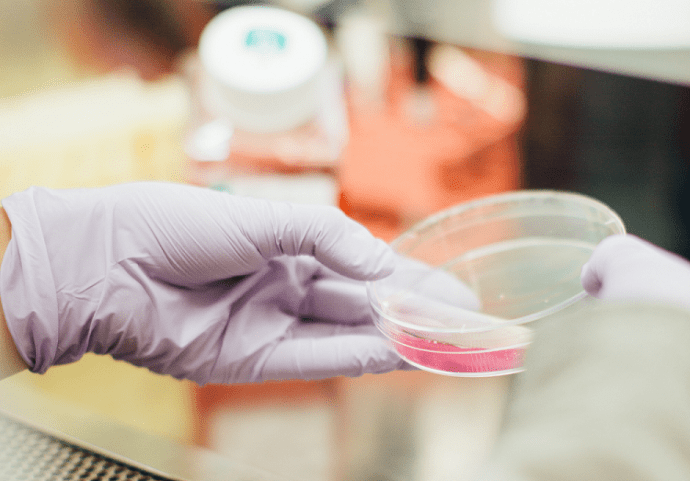

Με στόχο την ενημέρωση και την ευαισθητοποίηση της παγκόσμιας κοινότητας σε θέματα περιβάλλοντος, ο Οργανισμός Ηνωμένων Εθνών (ΟΗΕ) θεσμοθέτησε το 1972 την 5η Ιουνίου ως Παγκόσμια Ημέρα Περιβάλλοντος.
Με αφορμή αυτή την επέτειο, Καθηγητές του Εθνικού και Καποδιστριακού Πανεπιστημίου Αθηνών (ΕΚΠΑ), αρθρογραφούν σχετικά με το Περιβάλλον.
Ο Σάββας Γενίτσαρης, Επίκουρος Καθηγητής, Τμήμα Βιολογίας, Σχολή Θετικών Επιστημών, Εθνικό και Καποδιστριακό Πανεπιστήμιο Αθηνών (ΕΚΠΑ), περιγράφει τον αόρατο σπουδαίο κόσμο των μικρο-οργανισμών, ή πώς οι μικροβιακές κοινότητες κατέχουν το κλειδί της ζωής.
Οι μικροοργανισμοί, αν και αόρατοι με γυμνό μάτι, συνθέτουν ένα μεγάλο ποσοστό της βιοποικιλότητας του πλανήτη. Οι λειτουργίες τους ήταν μέχρι πρότινος αγνοημένες εξαιτίας της δυσκολίας παρατήρησής τους στα φυσικά τους περιβάλλοντα.
Ωστόσο, με την ανάπτυξη σύγχρονων τεχνολογιών ανάλυσης του DNA έχει αναγνωριστεί και περιγραφεί η σπουδαιότητα τους για τη ζωή στον πλανήτη. Μάλιστα, πολλοί καταξιωμένοι επιστήμονες έχουν υπογραμμίσει τη σημασία τους δηλώνοντας κατηγορηματικά ότι εξαφάνιση των μικροβίων θα συνεπαγόταν αυτόματη εξαφάνιση της ζωής στη Γη.
Και αυτό γιατί οι μικροοργανισμοί βρίσκονται παντού, ακόμα και σε ακραία ενδιαιτήματα με απαγορευτικές συνθήκες για τους μεγαλύτερους οργανισμούς, όπως όξινα περιβάλλοντα υδροθερμικών πηγών, ανοξικά ιζήματα, παγετώνες με χαμηλές θερμοκρασίες και θερμές πηγές κοντά στο σημείο βρασμού του νερού, με τεράστιους αριθμούς κυττάρων – δισεκατομμυρίων σε ένα γραμμάριο εδάφους ή σε ένα λίτρο νερού – κάνοντας τα πάντα:
Στηρίζουν τις τροφικές αλυσίδες στα υδατικά συστήματα ως οι κύριοι πρωτογενείς παραγωγοί στους ωκεανούς και τις λίμνες, παράγουν το 50 % του οξυγόνου παγκοσμίως, συμμετέχουν στους κύκλους όλων των απαραίτητων στοιχείων για τη ζωή, αποικοδομούν τη νεκρή οργανική ύλη, αποδομούν ρύπους με αποτέλεσμα να αποτοξικοποιούν ρυπασμένα περιβάλλοντα, ελέγχουν την υπέρμετρη αύξηση πληθυσμών ζώων και φυτών διατηρώντας την ισορροπία στα οικοσυστήματα, χρησιμοποιούνται καθημερινά και κατά κόρον από τον άνθρωπο για την παραγωγή τροφίμων όπως γαλακτοκομικών, ψωμιού, μπίρας και κρασιού, ενώ συμβάλλουν στην μείωση των επιπτώσεων της υπερθέρμανσης του πλανήτη αποτελώντας αποθήκες άνθρακα και εκκρίνοντας ενώσεις που προκαλούν ψύξη της ατμόσφαιρας.
Εξάλλου, ο πρώτος οργανισμός που εμφανίστηκε στη Γη, 4 περίπου δισεκατομμύρια χρόνια πριν, ήταν ένα μικρόβιο, ο πρόγονος όλης της ζωής με τη μορφή που την ξέρουμε. Η σύσταση της ατμόσφαιρας της γης σήμερα είναι αποτέλεσμα του μεγάλου οξειδωτικού γεγονότος περίπου 2,7 δισεκατομμύρια χρόνια πριν που οφείλεται στην εμφάνιση του πρώτου φωτοσυνθετικού οξυγονοπαραγωγικού μικροοργανισμού, ενός κυανοβακτηρίου, το οποίο διαμόρφωσε τη σημερινή συγκέντρωση οξυγόνου στον αέρα, προκάλεσε τη δημιουργία της στιβάδας του όζοντος, και έθεσε τις βάσεις για την εξέλιξη των ανώτερων οργανισμών.
Παρόλο που οι περισσότεροι θεωρούν τα μικρόβια ως αποκλειστικά παθογόνα και επικίνδυνα για τον άνθρωπο, στην πραγματικότητα το ανθρώπινο σώμα φιλοξενεί μεγαλύτερο αριθμό συμβιωτικών και ωφέλιμων βακτηριακών κυττάρων παρά ανθρώπινων κυττάρων.
Τα βακτήρια αυτά μας προστατεύουν από την μόλυνση με παθογόνα από τους βλεννογόνους και το δέρμα, διατηρούν την ομοιόστασή μας, ρυθμίζουν την πέψη, ενώ διαταραχή στη σύνθεσή τους μπορεί να συνδέεται με δυσλειτουργίες οργάνων και χρόνιες παθήσεις.
Η σημασία των μικροβιακών κοινοτήτων για το περιβάλλον και τον άνθρωπο καταδείχτηκε τις τελευταίες δεκαετίες με τη ραγδαία πρόοδο της επιστήμης και της τεχνολογίας και είναι πλέον κοινώς αποδεκτό ότι οι μικροοργανισμοί κρατούν το κλειδί της ζωής στον πλανήτη.